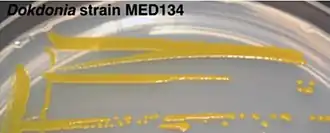

Dokdonia
| Dokdonia | ||||||||||||
|---|---|---|---|---|---|---|---|---|---|---|---|---|
Dokdonia donghaensis Stamm MED134 | ||||||||||||
| Systematik | ||||||||||||
| ||||||||||||
| Wissenschaftlicher Name | ||||||||||||
| Dokdonia | ||||||||||||
| Yoon et al. 2005 |
Dokdonia ist eine Gattung von Bakterien. Arten nutzen das Protein Proteorhodopsin, um mit Hilfe von Licht ATP zu erzeugen.
Erscheinungsbild
Die Zellen der Arten von Dokdonia sind stäbchenförmig. Flagellen sind nicht vorhanden, auch eine gleitende Bewegung („gliding motility“) wurde nicht beobachtet. Diese Bewegungsart findet man bei vielen anderen Arten der Flavobacteriaceae, auch bei der eng verwandten Gattung Cellulophaga. Sporen werden nicht gebildet. Die Kolonien sind gelb gefärbt.[1]
Stoffwechsel und Wachstum
Dokdonia ist auf Sauerstoff angewiesen, es ist strikt aerob. Der Katalase-Test und der Oxidase-Test fallen positiv aus. Nitrat wird nicht genutzt. Casein wird gespalten, Agar und Stärke werden nicht genutzt. Das dominierende Chinon ist das Menachinon-MK6. Der Gram-Test fällt negativ aus. Das Genom von D. donghaensis wurde vollkommen sequenziert.[2]
Es folgt eine Tabellen mit Merkmalen einiger Arten:[3][4][5][6]
| D. donghaensis | D. aurantiaca | D. flava | D. sinensis | |
|---|---|---|---|---|
| Zellgröße in μm | 0,3–0,6 × 1,5–25 | 0,68–0,76 × 1,76–3,04 | 0,80–0,89 × 2,24–3,84 | 0,5–0,8 × 1,0–3,0 µm |
| beste Wachstumstemperatur | 30 °C | 25 °C | 25 °C | 28 °C |
| bester Salzgehalt | 2 % | 4 % | 4 % | 2.0–3.0 % |
| tolerierte pH-Werte | 5,5–8,0 | 5,0–8,0 | 5,0–8,0 | 6,0–8,0 |
| bester pH-Wert | 7,0–8,0 | 7,0 | 7,0 | 7,0 |
Proteorhodopsin
Bei verschiedenen Stämmen Dokdonia wurden Funktion und Aufbau des Proteorhodopsins (PR) näher untersucht.[2][7] Bei Proteorhodopsin handelt es sich um ein Photoprotein, das als lichtgesteuerte Protonenpumpe in verschiedenen marinen Bakterien fungiert. Analog hierzu gibt es einen ähnlichen Mechanismus bei den Archeen (Bacteriorhodopsin). Hiermit wird Licht als Energiequelle genutzt, um ATP zu erzeugen. Es besteht aus einem einzelnen, von einer Membran umschlossenen Protein, das kovalent an ein lichtempfindliches Pigment gebunden ist.[2] Mit Hilfe der Lichtenergie werden hier Protonen (H+) vom Inneren der Zelle nach außen transportiert. Hiermit wird ein Konzentrationsunterschied zwischen den Protonen außerhalb (mehr) und innerhalb (weniger Protonen) der Zelle erzeugt. Dieser kann als Energielieferant für die Bildung von ATP durch die ATPase, die die Protonen wieder nach innen transportiert, genutzt werden. Dies dient als Ergänzung zu den ansonsten organischen Energiequellen (photoheterotrophes Wachstum) und kann bei Nahrungsmangel nützlich sein.[8] Die Nutzung von Licht durch das Proteorhodopsin darf nicht mit der Photosynthese verwechselt werden. So werden bei der Photosynthese Moleküle gebildet, bei dem photoheterotrophen Wachstum wird ausschließlich ATP produziert.
Der Stamm Dokdonia sp. PRO959 ist in der Lage, anstatt H+ auch Na+ für den Elektronentransport nach außen zu nutzen. Man spricht hierbei von dem Na+-Rhodopsin (NaR). Andere Bakterien, die hierbei ebenfalls Na+ nutzen, sind z. B. Nonlabens marinus, Nonlabens dokdonensis und Gillisia limnaea.[9]
Eine Vermutung geht davon aus, dass der durch das Proteorhodopsin erzeugte Protonengradient (pmf, proton motive force) dazu genutzt wird, Vitamin B1 (Thiamin) aufzunehmen. Das Vitamin B1 ist wichtig für den Kohlenstoffstoffwechsel, einschließlich des Citratzyklus.[10]
Die photische Zone des Ozeans enthält die größte Menge an PR, durchschnittlich 75 % aller im Plankton vorkommenden Bakterien besitzen die hierfür benötigten Gene.[10]
Ökologie
Alle bisher isolierten Arten von Dokdonia sind marin. Die Art Dokdonia lutea wurde von der Braunalge Sargassum fulvellum isoliert,[11] D. flava von dem Seegras Zostera marina im Gelben Meer.[5] D. aurantiaca wurde ebenfalls von Zostera marina isoliert.[4] Der Fundort der im Jahr 2020 beschriebenen Art D. sinensis lag im Meer bei der Xiaoshi-Insel (China).[6]
Systematik
Dokdonia zählt zu der Familie der Flavobacteriaceae. Die erste beschriebene Art, die zu der Gattung gestellt wurde, ist Dokdonia donghaensis.[3] Es ist somit die Typusart.
Dokdonia donghaensis wurde im Jahr 2005 in die Liste der beschriebenen Bakterien aufgenommen. (List of Prokaryotic names with Standing in Nomenclature, LPSN)[12][3]
Im Jahr 2012 wurden 3 Arten der Gattung Krokinobacter nach Dokdonia verschoben, diese Arten werden nun als Dokdonia genika, Dokdonia diaphoros und Dokdonia eikasta geführt.[13] 2015 folgte Dokdonia pacifica und bis zum Jahr 2020 wurden 5 weitere Arten beschrieben, wobei die 2018 beschrieben Art „Dokdonia ponticola“ noch nicht vollständig anerkannt ist.[12]
Es folgt eine Liste der bekannten Arten (Stand April 2024):[12]
- Dokdonia aurantiaca
- Dokdonia diaphoros
- Dokdonia donghaensis
- Dokdonia eikasta
- Dokdonia flava
- Dokdonia genika
- Dokdonia lutea
- Dokdonia pacifica
- "Dokdonia ponticola"
- Dokdonia sinensis
Einzelnachweise
- ↑ Noel R. Krieg u. a. (Hrsg.): Bergey’s Manual of Systematic Bacteriology. 2. Auflage, Band 4: The Bacteroidetes, Spirochaetes, Tenericutes (Mollicutes), Acidobacteria, Fibrobacteres, Fusobacteria, Dictyoglomi, Gemmatimonadetes, Lentisphaerae, Verrucomicrobia, Chlamydiae, and Planctomycetes. Springer, New York 2010, ISBN 978-0-387-68572-4, S. 201.
- ↑ a b c Kitae Kim, Soon-Kyeong Kwon, Jung-Hoon Yoon und Jihyun F. Kim: Complete Genome Sequence of the Proteorhodopsin-Containing Marine Flavobacterium Dokdonia donghaensis DSW-1T, Isolated from Seawater off Dokdo in the East Sea (Sea of Korea) In: Genome Announcements, 4(4), 4 August 2016 doi:10.1128/genomeA.00804-16
- ↑ a b c Jung-Hoon Yoon, So-Jung Kang, Choong-Hwan Lee und Tae-Kwang Oh: Dokdonia donghaensis gen. nov., sp. nov., isolated from sea water In: International Journal of Systematic and Evolutionary Microbiology (2005), 55, 2323–2328, DOI:10.1099/ijs.0.63817-0
- ↑ a b Seon Choi, Joo Won Kang, Mi Sun Kim, Jung-Hoon Yoon und Chi Nam Seong: Dokdonia aurantiaca sp. nov., isolated from seaweed Zostera marina. In: International Journal of Systematic and Evolutionary Microbiology (2018), Band 68: S. 1697-1701 doi:10.1099/ijsem.0.002730
- ↑ a b Seon Choi, Joo Won Kang, Jung-Hoon Yoon und Chi Nam Seong: Dokdonia flava sp. nov., isolated from the seaweed Zostera marina In: International Journal of Systematic and Evolutionary Microbiology (2018) Band 68: S. 899–904 doi:10.1099/ijsem.0.002607
- ↑ a b Liu-Yan Zhou, Xue Meng, Yan-Lin Zhong, Guang-Yu Li, Zong-Jun Du und Da-shuai Mu: Dokdonia sinensis sp. nov., a flavobacterium isolated from surface seawater In: International Journal of Systematic and Evolutionary Microbiology (2020) Band 70, Ausgabe 3 doi:10.1099/ijsem.0.003949
- ↑ Hiroyuki Kimura, Curtis R Young, Asuncion Martinez & Edward F DeLong: Light-induced transcriptional responses associated with proteorhodopsin-enhanced growth in a marine flavobacterium In: The ISME Journal, Band 5, S. 641–1651 (2011) doi:10.1038/ismej.2011.36
- ↑ Qing Liu, Hong-Can Liu, Yu-Guang Zhou und Yu-Hua Xi: Microevolution and Adaptive Strategy of Psychrophilic Species Flavobacterium bomense sp. nov. Isolated From Glaciers In: Frontiers in Microbiology, 22. Mai 2019, Band 10, S. 1069. doi:10.3389/fmicb.2019.01069.
- ↑ Alexander V. Bogachev, Yulia V. Bertsova, Marina L. Verkhovskaya, Mahir D. Mamedov und Vladimir P. Skulachev: Real-time kinetics of electrogenic Na+ transport by rhodopsin from the marine flavobacterium Dokdonia sp. PRO95 In: Scientific Reports Band 6, Artikel Nummer: 21397 (2016) doi:10.1038/srep21397
- ↑ a b Laura Gómez-Consarnau, José M González, Thomas Riedel, Sebastian Jaenicke, Irene Wagner-Döbler, Sergio A Sañudo-Wilhelmy und Jed A Fuhrman : Proteorhodopsin light-enhanced growth linked to vitamin-B1 acquisition in marine Flavobacteria In: The ISME Journal Band 10, S. 1102–1112 (2016) doi:10.1038/ismej.2015.196
- ↑ Seon Choi, Joo Won Kang, Ji Hee Lee und Chi Nam Seong: Dokdonia lutea sp. nov., isolated from Sargassum fulvellum seaweed In: International Journal of Systematic and Evolutionary Microbiology (2017) Band 67, S. 4482–4486 doi:10.1099/ijsem.0.002317
- ↑ a b c Jean Euzéby, Aidan C. Parte: Genus Dokdomnia. In: List of Prokaryotic names with Standing in Nomenclature (LPSN). Abgerufen am 17. April 2024.
- ↑ Reclassification of the three species of the genus Krokinobacter into the genus Dokdonia as Dokdonia genika comb. nov., Dokdonia diaphoros comb. nov. and Dokdonia eikasta comb. nov., and emended description of the genus Dokdonia Yoon et al. 2005 In: International Journal of Systematic and Evolutionary Microbiology (2012), Band 62, S. 1896–1901 doi:10.1099/ijs.0.035253-0
Literatur
- Noel R. Krieg u. a. (Hrsg.): Bergey’s Manual of Systematic Bacteriology. 2. Auflage, Band 4: The Bacteroidetes, Spirochaetes, Tenericutes (Mollicutes), Acidobacteria, Fibrobacteres, Fusobacteria, Dictyoglomi, Gemmatimonadetes, Lentisphaerae, Verrucomicrobia, Chlamydiae, and Planctomycetes. Springer, New York 2010, ISBN 978-0-387-68572-4, S. 201.